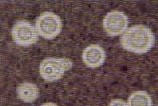

|
|
Περισσότερα
επιστημονικά θέματα στις συνδέσεις: |
|
|
|
||
|
Microsporum
gallinae
Cryptococcus neoformans
Asperillus fumigatus
Βιοψία οισοφάγου από ασθενή με
ηωσινοφιλική οισοφαγίτιδα. Ο βλεννογόνος έχει άνω των 20
ηωσινόφιλα κ.ο.π. Χρώση: Η & Ε Μεγέθυνση: x400
|
|
ενδιαφέροντα
ιατρικά θέματα
ΙΑΤΡΙΚΕΣ ΕΞΕΛΙΞΕΙΣ
Μύκητες ιατρικού ενδιαφέροντος και επιπολής μυκητιάσεις
Οι μύκητες είναι ευκαρυωτικοί
μικροοργανισμοί. Μόνο 15 γένη και
περίπου 100 είδη από τις χιλιάδες των ειδών μυκήτων ευθύνονται για νόσο στον
άνθρωπο. Οι περισσότεροι από τους μύκητες
ιατρικού ενδιαφέροντος έχουν κοσμοπολίτικη κατανομή και βρίσκονται παντού. Οι επιπολής μυκητιάσεις
προσβάλλουν τα μέρη του σώματος που περιέχουν κερατίνη (επιδερμίδα, τρίχες,
νύχια κλπ.). Αυτές οι λοιμώξεις
γενικά θεωρούνται αισθητικά προβλήματα και δεν θέτουν σε κίνδυνο τη ζωή. Σπανιότατα και μόνο σε άτομα σοβαρά
ανοσοκατασταλμένα επεκτείνονται σε άλλους ιστούς. Τα παιδιά είναι περισσότερο ευαίσθητα και οι λοιμώξεις είναι
συχνότερες σε περιοχές με θερμό και υγρό κλίμα. Τα συχνότερα αίτια επιπολής
μυκητιάσεων είναι τα είδη Trichophyton, Microsporum, και ένα είδος Epidermophyton, που ομαδικά αναφέρονται ως
δερματόφυτα. Άλλοι μύκητες που
προκαλούν επιπολής μυκητιάσεις περιλαμβάνονται στα είδη Pityrosporum και Candida. Οι κλινικές εκδηλώσεις είναι απολέπιση
του δέρματος, τριχόπτωση, κνησμός και ερύθημα ή άλλη δυσχρωμία. Η συμπτωματολογία είναι χαρακτηριστική,
αλλά δεν είναι επαρκής. Έτσι για να
τεθεί ακριβής διάγνωση απαιτείται ειδικός εργαστηριακός έλεγχος [Οι μικροσκοπικές εικόνες των
μυκήτων αριστερά έχουν ληφθεί από το βιβλίο της Ο. Σπυράκου: Βασική Ιατρική
Μυκητολογία, 2η έκδ., Αθήνα, 2000.] Δείκτης
ποιότητας σπέρματος (SFI)
Ο δείκτης ποιότητας σπέρματος (SFI) χρησιμοποιείται για εκτίμηση της ικανότητας συγκεκριμένου σπέρματος προς γονιμοποίηση. Για τον αριθμητικό υπολογισμό του SFI έχει
σχεδιαστεί ένα λογισμικό που συνυπολογίζει διάφορες παραμέτρους τυπικά
προσδιοριζόμενες κατά την εξέταση σπέρματος (αριθμός, μορφολογία και
κινητικότητα σπερματοζωαρίων, βιοχημικές εξετάσεις, παρουσία αντισπερματικών
αντισωμάτων). Σύμφωνα με την κατάταξη αυτή ένα εντελώς
φυσιολογικό σπέρμα έχει SFI μεγαλύτερο από 160 AU. Τιμές SFI μεταξύ 80 και 160 AU υποδηλώνουν μέτριας ποιότητας
σπέρμα. Τέλος τιμές SFI μικρότερες
των 80 AU ανευρίσκονται σε προβληματικά σπέρματα με εξαιρετικά μικρή
ικανότητα για γονιμοποίηση. [Στην εικόνα επάνω παρατίθεται
σπερμοδιάγραμμα μέτριας ποιότητας σπέρματος (SFI = 122 AU), που παρουσιάζει
συγκολλήσεις και είναι θετικό για παρουσία αντισπερματικών αντισωμάτων με MAR
test. Αριστερά μικροσκοπική εικόνα
σπέρματος] Ηωσινοφιλική οισοφαγίτιδα σε ασθενείς με άσθμα Το άσθμα είναι μια συχνή νόσος που προσβάλλει 8-10% των ενήλικων. Από την άλλη πλευρά η ηωσινοφιλική οισοφαγίτιδα είναι μια σχετικά “νέα” νόσος που συναντάται σε ποσοστό μέχρι 0,4% του πληθυσμού. Το επιδημιολογικό εύρημα που συνδέει τα δύο νοσήματα είναι το γεγονός ότι περίπου 50% των ασθενών με ηωσινοφιλική οισοφαγίτιδα πάσχουν ταυτόχρονα από άσθμα. Ετσι κάποιοι ασθενείς με άσθμα θα παρουσιάσουν κάποια στιγμή ηωσινοφιλική οισοφαγίτιδα. Το ερώτημα είναι αν η οισοφαγίτιδα προκαλείται από το άσθμα, από την αιτία που προκάλεσε το άσθμα ή από τη θεραπεία του άσθματος. Μια έρευνα που έγινε το 2013 στη Mayo Clinic με συνεργασία πνευμονολόγων και γαστρεντερολόγων κατέληξε στο συμπέρασμα ότι το αλλεργικό άσθμα, η αλλεργική ρινίτιδα και η περιφερική ηωσινοφιλία (ιδιαίτερα από δραστικά ηωσινόφιλα) συνδέονται με εμφάνιση ηωσινοφιλικής οισοφαγίτιδας. Αντίθετα η χρήση εισπνεόμενων κορτικοστεροειδών ασκεί προστατευτική επίδραση στην εμφάνιση ηωσινοφιλικής οισοφαγίτιδας. Από τα αποτελέσματα της έρευνας προκύπτει ότι η ηωσινοφιλική οισοφαγίτιδα
πρέπει να αντιμετωπίζεται ως γενικευμένη αλλεργική νόσος μάλλον, παρά ως
τοπικό νόσημα του οισοφάγου. UMMA test: Η καλύτερη εξέταση για
την ανίχνευση έλλειψης βιταμίνης Β12 Ο ρόλος της βιταμίνης Β12 είναι σημαντικός για τη σύνθεση του DNA, την ερυθροποίηση, το σχηματισμό και τη συντήρηση του περιβλήματος μυελίνης των νεύρων. Η έλλειψη Β12 μπορεί να προκαλέσει κακοήθη αναιμία, νευρολογικές βλάβες π.χ. εκφύλιση του νωτιαίου μυελού και νοητικές μεταβολές. Αν αφεθεί χωρίς θεραπεία υπολογίζεται ότι 80 - 90% των ατόμων με έλλειψη θα εμφανίσουν διαταραχές από το νευρικό σύστημα όπως καταβολή, μυαλγίες, μείωση της οπτικής οξύτητας, κατάθλιψη, σύγχυση, απώλεια μνήμης ή άνοια παρόμοια με της νόσου Alzheimer και παράλυση των κάτω άκρων. Επίσης πρόσφατες έρευνες δείχνουν πως η έλλειψη Β12 μπορεί να είναι αιτία καρδιακού ή εγκεφαλικού επεισοδίου. Διάφορες εργαστηριακές μέθοδοι έχουν χρησιμοποιηθεί για τον έλεγχο επιλεγμένων ατόμων, όπως ο προσδιορισμός της βιταμίνης Β12 στο αίμα, το Schilling test και η ομοκυστεΐνη του πλάσματος, αλλά όλες αυτές οι εξετάσεις δίνουν συχνά ψευδώς θετικές ή ψευδώς αρνητικές τιμές. Αυξημένα επίπεδα μεθυλομηλονικού οξέος στα ούρα (UMMA) είναι ενδεικτικά ιστικής/κυτταρικής έλλειψης Β12, αφού σχετίζονται άμεσα με μια μεταβολική οδό εξαρτημένη από τη Β12: Συνένζυμο
Β12 Μεθυλομηλονικό οξύ ——————→ Ηλεκτρικό οξύ Η έλλειψη βιταμίνης Β12 παρεμποδίζει αυτή τη μεταβολική οδό με αποτέλεσμα να αυξάνεται η αποβολή μεθυλομηλονικού οξέος στα ούρα. Φυσιολογικά το μεθυλομηλονικό οξύ των ούρων (UMMA) είναι λιγότερο από 3,8 μg / mg κρεατινίνης. Πολλοί ερευνητές έχουν αποδείξει πως ο προσδιορισμός του UMMA υπερβαίνει κατά πολύ σε αξιοπιστία όλες τις άλλες εξετάσεις για την πρώιμη διάγνωση της έλλειψης βιταμίνης Β12 καθώς και για την παρακολούθηση της βελτίωσης μετά την έναρξη θεραπείας. IAST® :
Σύγχρονη εργαστηριακή μέθοδος διάγνωσης της αναπνευστικής αλλεργίας Στις αναπτυγμένες χώρες δύο στους δέκα είναι
αλλεργικοί. Η αλλεργία όμως συχνά
παρουσιάζεται με άτυπη, όχι ξεκάθαρη συμπτωματολογία. Έτσι σε σημαντικό βαθμό η διάγνωση της αλλεργίας
δύσκολα τεκμηριώνεται. Μια σύγχρονη λύση σ' αυτό το πρόβλημα αποτελεί η
μέθοδος IAST® (Inhalation Allergy Screen Test). To IAST είναι μια απλή και αξιόπιστη εξέταση αίματος για την
τεκμηρίωση ή τον αποκλεισμό της αλλεργίας σε ασθενείς με συμπτώματα από το
ανώτερο ή κατώτερο αναπνευστικό σύστημα, τα μάτια ή και τα αυτιά. Ένα δείγμα αίματος 0,50 ml αρκεί για την
εκτέλεση της εξέτασης, που μπορεί να γίνει σε κάθε εξοπλισμένο διαγνωστικό
εργαστήριο. Τα αποτελέσματα δίνονται
σε AU/L (μονάδες αλλεργίας). Η φυσιολογική τιμή είναι 0-35 AU/L. Κλινικές έρευνες που έγιναν στα Ιατρικά Διαγνωστικά Εργαστήρια δείχνουν συμφωνία άνω του 95% με τις συμβατικές πολύπλοκες και δαπανηρές διαγνωστικές μεθόδους.
|